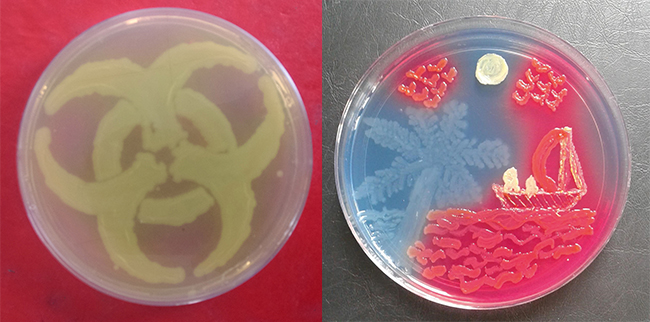
MT Nov 16 agar art 1st-3rd

Agar art competition in Nepal
Budding artists in Nepal have taken part in an agar art competition – the first to have been organised between the Microbiology Society and local host partner organisation, Amazing Microbiology Nepal.
Society Champion, Manoj Pradhan, is the person behind Amazing Microbiology Nepal, which is primarily a Facebook group sharing ideas but the group also organises events, workshops and conferences too. He said, “The main objective behind organising the agar art contest was to reach a wider audience and make them more aware not only of the Microbiology Society, but also the opportunities the study of microbiology brings for researchers, students and academics. I think we have achieved our goal.” Manoj went on to say that the competition had already generated a lot of interest and that group members were busy answering many queries resulting from it.
The competition saw 51 entries from 12 different institutions across Nepal. Entries were judged on both their creative and microbiological content. First prize (below left) went to Nisha Pote from Dhulikhel Hospital; second prize went to Binita Adhikari from Nepalese Army Institute of Health Science, while third prize (below right) went to Monika Maharjan from St Xavier’s College.
The Society is delighted to have supported Manoj in this competition. Nepal has been through some challenging times recently and we are very pleased to have members in the country who can still find time to support initiatives like this.
PAUL EASTON
Head of Membership Services
[email protected]
